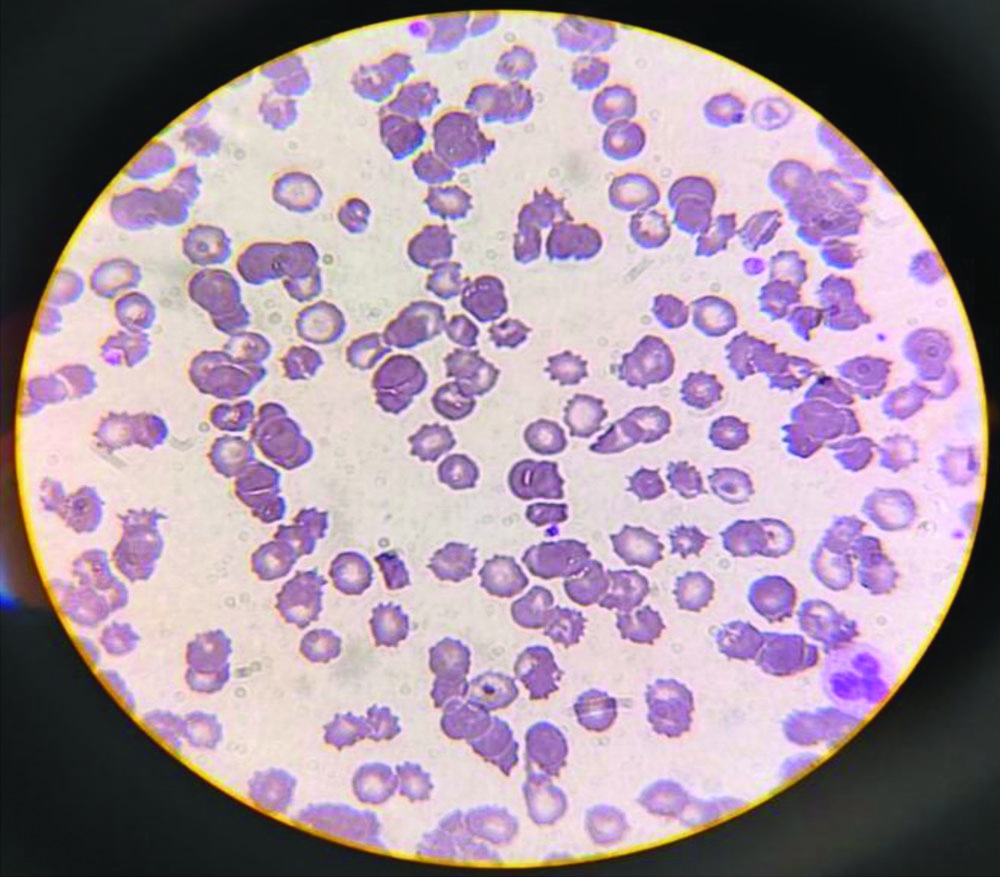
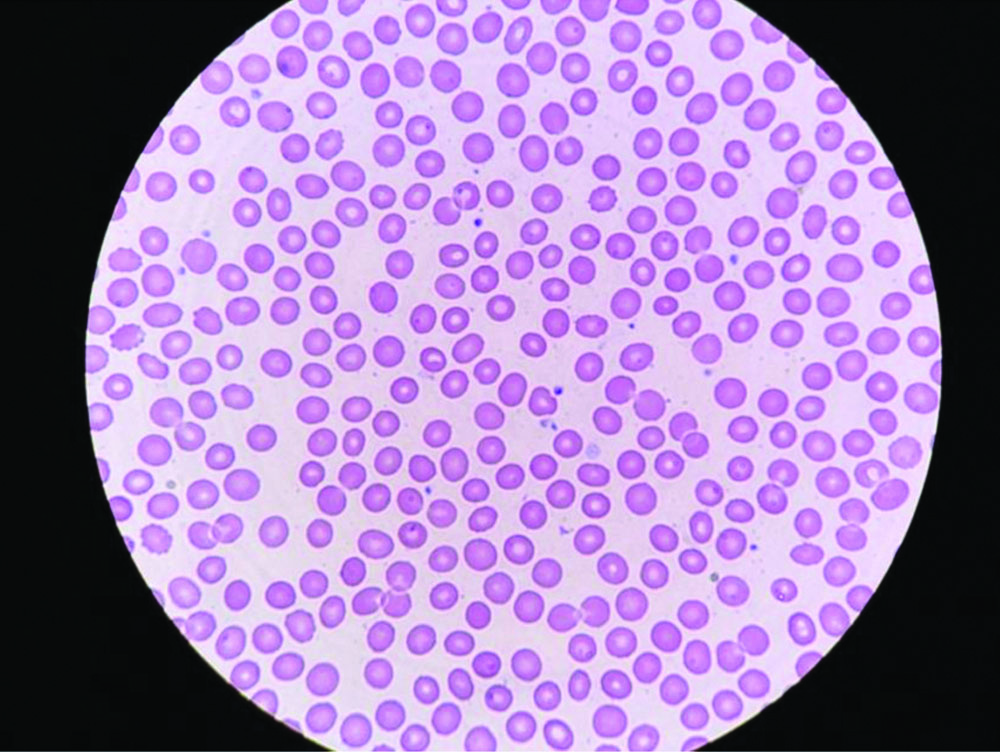

Introduction
Thrombocytopenia, characterised by a decreased platelet count below the normal range, poses unique challenges in pregnancy, a physiological state marked by various haemostatic alterations. Although an increase in coagulation factors and blood volume is typically associated with pregnancy, thrombocytopenia introduces potential complications that demand careful clinical consideration. This condition can arise from various aetiologies, including gestational thrombocytopenia, Immune Thrombocytopenic Purpura (ITP), preeclampsia, and other underlying medical conditions. Thrombocytopenia in pregnancy not only affects maternal health but also raises concerns about foetal well-being and potential impacts on delivery outcomes. Understanding the complexities of thrombocytopenia in pregnancy is essential for healthcare providers to effectively navigate its diagnosis, treatment, and subsequent care [1,2]. Hereby, authors present six cases of thrombocytopenia in pregnancy and their management strategies.
Case 1
A 29-year-old primigravida at 35 weeks and five days was admitted for safe confinement due to immune thrombocytopenia. She was diagnosed with a low platelet count (0.85 L/per mm3) at 19 weeks of pregnancy. She was a known case of hypothyroidism and was on tablet thyroxine, 37.5 mcg once daily. A peripheral smear [Table/Fig-1] revealed microcytic hypochromic anaemia with thrombocytopenia. A haematologist’s opinion was obtained. The patient was advised to monitor her platelet count monthly and to seek further review if, the count dropped below 50,000.
Peripheral smear showing low platelet count.
At 25 weeks of gestation, her platelet count was 0.9 L/mm3, which decreased to 0.73 L/mm3 at 30 weeks, followed by 0.61 L/mm3 at 34 weeks. The patient was diagnosed with probable immune thrombocytopenia based on the pattern of decreasing platelet counts. Weekly platelet monitoring was conducted, and the haematologist advised starting tab Prednisolone at 1 mg/kg/day in divided doses if, the platelet count dropped below 0.5 L/mm3. The patient had a history of bleeding gums and petechial lesions on her skin and was admitted for steroid coverage. Steroid coverage was provided with intravenous Dexamethasone.
At 35 weeks, her platelet count was 0.9 L/mm3. Three days later, her platelet count dropped to 0.58 L/mm3. Considering the possibility of immune thrombocytopenia, the patient was started on Inj. Methylprednisolone 1 gm in 500 mL normal saline intravenously once daily for three days (pulse steroid), followed by oral steroids (Tab Prednisolone at 1 mg/kg) as advised by the haematologist. Her platelet count began to improve. Three units of platelets were transfused, and the patient was taken up for emergency Lower Segment Caesarean Section (LSCS) under general anaesthesia due to foetal distress at 36 weeks. She delivered a healthy baby boy with a birth weight of 1.73 kg.
From the second postoperative day, tab Wysolone at 1 mg/kg/day was restarted and continued for five days. Her postoperative platelet count improved to 1.13 L/mm3 after three weeks of delivery. The steroids were tapered. Her symptoms improved, and she was subsequently discharged. The improvement in platelet count after steroid therapy and the baseline platelet count of 0.1 L/mm3 made the diagnosis of immune thrombocytopenia evident. The patient was reviewed after two weeks, with a platelet count of 1.12 L/mm3, and she was symptomatically better and advised to continue steroid therapy.
Case 2
A 23-year-old primigravida at 37 weeks with monochorionic-diamniotic twins presented in early labour with reports indicating deranged liver function tests and a low platelet count with gestational age of 36 weeks and 5 days and had experienced one episode of elevated blood pressure of 140/90 mmHg at 36 weeks. She exhibited bilateral grade 1 pitting pedal oedema. Her Haemoglobin (Hb) was 11.7 g/dL, D-dimer was 413, and platelets were 1.3 L/mm3 with a normal coagulation profile and normal spot Polymerase Chain Reaction (PCR). She was diagnosed with partial HELLP syndrome. The patient was taken for an emergency caesarean section due to the monochorionic diamniotic twins in labour and delivered two live and healthy babies. Given the deranged liver function, she was started on Ursodeoxycholic acid 600 mg twice daily for five days. Her postoperative period was uneventful. Postdelivery, her platelet levels improved to 2 L/mm3. A medical gastroenterologist advised the continuation of Ursodeoxycholic acid. She was discharged with antibiotics and vitamin supplements after symptomatic recovery. Upon review two weeks later, she had normal platelet counts and liver function tests.
Case 3
A 26-year-old gravida 3, para 0 patient was admitted at 40 weeks of gestation for safe confinement. She had a history of anaemia, which was corrected with four units of iron sucrose at 32 weeks of gestation. She had two previous abortions: one at two months of gestation five years ago and another at three months of gestation one year ago. For both of these, Dilation and Curettage (D&C) was not performed. She was diagnosed with hypothyroidism at 17 weeks of gestation and was started on tablet thyroxine 12.5 mcg once daily. She also has a history of appendectomy performed in 2022.
Her physical examination was normal, and on abdominal examination, her uterus was corresponding to the dates. Her platelet counts were 1.35 L/mm3 at 37 weeks and 1.26 L/mm3 at 39 weeks. She underwent an emergency LSCS due to cephalopelvic disproportion at 40 weeks. She delivered a healthy baby weighing 3.4 kg. Postdelivery, her platelet count improved to 2.07 L/mm3 on postoperative day 3, and she was discharged with a diagnosis of gestational thrombocytopenia.
Case 4
A 34-year-old primigravida, with a gestational age of 36 weeks and five days, was admitted due to moderate anaemia. The patient reported no complaints of abdominal pain, leaking, bleeding, or spotting per vagina. She denied experiencing fever, vomiting, burning micturition, or any white discharge or trauma. The patient had a history of hypothyroidism, diagnosed in the 5th month of pregnancy, for which she was initially started on tablet Thyroxine 12.5 mcg once daily, later increased to 50 mcg once daily in the 7th month. She had no other co-morbidities. The patient had a history of blood transfusion five years ago due to severe anaemia (Hb 3 g/dL).
On examination, the patient showed no signs of pallor but presented with pedal oedema. Her vital signs were stable, and systemic examinations were within normal limits. The uterus corresponded to 36 weeks of gestation, the foetal presentation was breech, and the foetal heart rate was normal.
Complete Blood Count (CBC) results indicated a gradual decline in haemoglobin levels and platelet counts:
At 27 weeks: Hb 9.7 g/dL, Platelet count 1.13 L/mm3
At 36+5 weeks: Hb 9.4 g/dL, Platelet count 1.13 L/mm3
At 36+6 weeks: Hb 8.7 g/dL, Platelet count 0.81 L/mm3
The peripheral blood smear [Table/Fig-2] revealed normocytic normochromic anaemia, along with varying degrees of thrombocytopenia and leukopenia. The Dengue IgG test was positive. Other investigations, including urine routine, serological tests, serum calcium, d-dimer, and fibrinogen assay, were normal. A general physician’s opinion was sought regarding the anaemia and low platelet count, and the patient was transfused with one unit of Packed Red Blood Cells (PRBC). Serum B12 and folate levels were found to be normal. Iron sucrose was administered on three occasions, two days apart. An emergency LSCS was performed due to a breech presentation in labour. Intraoperatively, one unit of PRBC was transfused. Postoperatively, CBC and coagulation profile monitoring were conducted. The patient improved clinically, and a rising trend in platelet count was noted, leading to a diagnosis of gestational thrombocytopenia. The platelet count increased progressively from Postoperative Day (POD) 1 to POD 10, indicating a positive trend in platelet levels, as represented in [Table/Fig-3].
Peripheral blood smear showing thrombocytopenia with normocytic normochromic red blood cells.
| POD | 1 | 2 | 3 | 5 | 6 | 7 | 8 | 10 |
|---|
| Platelet (L/mm3) | 0.60 | 0.77 | 0.66 | 0.85 | 0.87 | 1.04 | 1.14 | 1.4 |
The patient was discharged and advised to follow-up with CBC and coagulation profiles. She was reviewed after two weeks, and the CBC showed normal platelet levels.
Case 5
A pregnant woman in her mid-20s, Gravida 2 (second pregnancy), Para 1 (one previous delivery or abortion) (G2A1), was admitted with a gestational age of 26 weeks and two days, presenting a two-day history of fever and body aches. She had no history of abdominal pain, nausea, vomiting, headache, loose stools, or any bleeding manifestations. The patient had a history of thyroiditis, mild anaemia, and a previous admission for abdominal pain at 23 weeks, where she was diagnosed with mild right hydroureteronephrosis.
On examination, the patient was conscious and febrile, with a temperature of 100°F. She was found to be pale. Vital signs were stable, and the uterus was palpable at 26 to 28 weeks. Baseline investigations showed a haemoglobin level of 9.5 gm% and a low platelet count of 1.26 L/mm3. Fever evaluation was conducted, and the dengue Nonstructural protein 1 (NSI) antigen test returned positive. A physician’s opinion was obtained, and the patient was diagnosed with dengue fever and extended dengue syndrome. Conservative management was initiated with daily blood count monitoring.
The patient was eventually transferred to the Intensive Care Unit (ICU) due to hypotension and decreasing platelet counts. She received adequate hydration with intravenous fluids. The patient symptomatically improved, and platelet counts increased to 2.76 L/mm3 after six days. The patient was discharged with a diagnosis of resolved dengue fever with thrombocytopenia. She was advised to continue her thyroid medication and attend regular antenatal check-ups. Close monitoring of foetal well-being was recommended. A follow-up with repeat platelet counts was advised, and they were found to be normal. The patient was educated about warning signs and symptoms to monitor.
Case 6
The patient, a 30-year-old G2A1 woman at 32 weeks and six days of gestation, conceived through ovulation induction. She presented with complaints of vomiting, headache, and blurred vision. During the second trimester, she was diagnosed with gestational hypertension, hypothyroidism, and bronchial asthma. The patient received magnesium sulfate and steroid coverage due to severe preeclampsia. Her first trimester was unremarkable; however, in the second trimester, she was diagnosed with gestational hypertension at 26 weeks, initially managed with Labetalol 100 mg three times daily. At 29 weeks of gestation, the antihypertensives were switched to Labetalol 200 mg three times a day and Nicardipine 10 mg twice daily. The patient was admitted at 31 weeks due to elevated blood pressure and received magnesium sulfate and steroid coverage.
The patient had a five-year history of hypothyroidism, managed with Thyroxine 25 mcg once daily. She was also a known case of bronchial asthma treated with Salmeterol and Fluticasone inhalers. On examination, the patient was afebrile, without pallor, and had bilateral pedal oedema. Cardiovascular and respiratory examinations were normal. Her blood pressure was 130/90 mmHg, pulse rate was 82/minute, and abdominal examination indicated a uterus corresponding to 32 weeks with a good foetal heart rate. The cervix was soft, posterior, uneffaced, and closed.
The patient was admitted with severe preeclampsia and imminent signs of eclampsia. Her haemoglobin was 6.7 gm, and her platelet count was 0.5 L/mm3. Laboratory investigations revealed deranged liver function tests, features of haemolysis, and neutrophilic leukocytosis. Urine protein was 3+, and spot PCR was 1.365. Emergency LSCS was performed on 18/10/23 due to impending eclampsia with an unfavorable cervix and HELLP syndrome. A preterm baby with a birth weight of 1.3 kg was delivered. Intraoperatively, the patient received blood products, and following the emergency LSCS, she was transferred to the ICU.
Postoperatively, she was managed with magnesium sulfate for neuroprotection and antihypertensives. The patient was transfused with four units of Fresh Frozen Plasma (FFP), four units of platelets, two units of cryoprecipitate, and one unit of PRBC. An ophthalmologic evaluation revealed a normal bilateral fundus examination. A general medicine consultation was sought, and she was started on Labetalol 100 mg three times daily and Nicardipine 10 mg three times daily. The patient’s blood pressure was diligently monitored, and she remained normotensive throughout the postoperative period, contributing to her overall stable condition. Platelet counts improved to 0.63 L/mm3 after LSCS on the first postoperative day.
Both the patient and the baby stabilised, and she was discharged with a platelet count of 1.58 L/mm3. The patient was advised to continue antihypertensives and to return for a CBC review one week following discharge. Upon review after a week, her CBC showed a platelet count of 1.67 L/mm3 and normal liver function tests.
Discussion
Thrombocytopenia in pregnancy refers to a condition characterised by a decreased platelet count, presenting unique challenges and considerations in the management of expectant mothers. Because platelets are essential for blood coagulation and preventing excessive bleeding, having an adequate number of them during pregnancy, labour, and the postpartum period is essential [3]. Thrombocytopenia in pregnancy can have various causes, ranging from benign and self-limiting conditions to more serious underlying disorders. One common cause is gestational thrombocytopenia, which typically occurs in the second or third trimester [4]. This benign condition is thought to result from increased plasma volume during pregnancy, leading to a relative decrease in platelet concentration. Gestational thrombocytopenia is generally mild and resolves spontaneously without adverse effects on the mother or baby [4].
Immune Thrombocytopenic Purpura (ITP) is an autoimmune disorder that can lead to thrombocytopenia during pregnancy. In this condition, the human body produces antibodies that attack platelets, resulting in a decreased platelet count. Careful management is required to prevent complications during pregnancy and delivery [5].
Preeclampsia, a hypertensive disorder specific to pregnancy, is another significant cause of thrombocytopenia. In preeclampsia, there is widespread endothelial dysfunction and reduced blood flow to various organs, which affects platelet function and count. Severe preeclampsia may lead to HELLP syndrome, a potentially life-threatening condition for both the mother and the baby. Underlying medical conditions, including Antiphospholipid Syndrome (APLAS) and Systemic Lupus Erythematosus (SLE), can also contribute to thrombocytopenia during pregnancy. These autoimmune disorders can cause immune-mediated destruction of platelets or interfere with normal blood clotting mechanisms [6]. Determining the specific cause of thrombocytopenia in pregnancy is crucial for appropriate management and ensuring the best possible outcomes for both the mother and the developing foetus.
Diagnosing thrombocytopenia in pregnancy involves a comprehensive assessment that considers various potential causes. Routine prenatal blood tests, including a CBC, reveal the platelet count. A platelet count below the normal range of 150,000 to 450,000 platelets per microliter may indicate thrombocytopenia. Additional tests, such as peripheral blood smears and blood clotting profiles, help identify specific causes like ITP or preeclampsia [7]. A thorough medical history, including any prior history of thrombocytopenia or autoimmune disorders, aids in determining the most accurate diagnosis and tailoring an appropriate management plan for the pregnant individual. Regular monitoring during pregnancy ensures timely intervention if needed.
The fundamental cause and extent of thrombocytopenia during pregnancy are the main determinants of the course of therapy. In cases where the low platelet count is mild and not associated with bleeding complications, close monitoring may be the sole approach. However, more severe cases or those linked to specific disorders may necessitate intervention. For ITP, corticosteroids such as prednisone are commonly prescribed to suppress the immune response and increase platelet production. Intravenous Immunoglobulin (IVIG) may also be administered to boost platelet levels. In cases where thrombocytopenia is linked to preeclampsia, managing the underlying condition is crucial. The diagnosis and management of thrombocytopenia in pregnancy requires close attention to personal and family history, pregestational platelet counts, time of onset, severity and accompanying clinical and laboratory findings [8]. This may involve hospitalisation, close blood pressure monitoring, and delivery of the baby if, the pregnancy is at an advanced stage. Platelet transfusions are considered in severe cases or if, there is a risk of bleeding during childbirth. However, the decision to administer platelet transfusions is carefully weighed against potential risks and is typically reserved for critical situations due to associated complications.
Gestational thrombocytopenia is the most common cause of low platelet counts during pregnancy and poses no risk to the mother or baby. ITP is diagnosed by ruling out other causes and is often present before pregnancy. Most cases of ITP during pregnancy do not require treatment. Preeclampsia and HELLP syndrome can also cause low platelet counts, sometimes necessitating early delivery [9]. Careful observation is necessary for pregnant individuals with normal platelet counts who have experienced Neonatal Alloimmune Thrombocytopenia (NAT) in a previous pregnancy or in the offspring of family members. Testing for antiplatelet antibodies in the mother’s and baby’s blood can determine the presence of antibodies in maternal plasma, their reactivity with the baby’s platelets, and the immunological sensitivity of the parental and embryonic platelets (with appropriate typing). Antigenic typing of the father’s platelets helps assess the risk of NAT in the current pregnancy. If, severe immune-mediated thrombocytopenia is suspected in the foetus due to autoantibodies or alloantibodies, foetal platelet counts should be measured, ideally by puncturing the umbilical cord. If the number of foetal platelets is less than 50,000/μL or cannot be measured but is likely to be low, caesarean delivery should be strongly considered [10]. It has been demonstrated 30 that prenatal administration of IVIG reduces the risk of intracranial hemorrhage and improves outcomes in fetuses and newborns [10].
Thrombotic microangiopathy, including Thrombotic Thrombocytopenic Purpura (TTP) and Complement-mediated (CM) Haemolytic Uraemic Syndrome (HUS), is rare during pregnancy and can be difficult to distinguish from other conditions like preeclampsia [11]. Close monitoring and multidisciplinary care can improve outcomes. Treatment decisions for ITP and HUS during pregnancy are challenging due to limited research on new therapies, such as thrombopoietin-receptor agonists or eculizumab, requiring a careful balance of potential benefits against risks to both the mother and baby.
A diagnostic strategy for women with thrombocytopenia during pregnancy emphasises the minor variations in physical assessment, clinical course, appearance, and laboratory results that can help narrow the range of possibilities [11]. Preeclampsia, immune system suppression, and other prevalent causes of neutropenia during pregnancy were highlighted in four clinical scenarios, along with their pathogenesis and management [12]. The case presented involved a patient with ITP, in which the diagnosis was made early in the pregnancy. First-line therapy for this condition included high-dose steroid hormones, injectable immune globulin, and other splenectomy-sparing methods such as lymphoma treatment. Control of the condition was achieved in the third trimester following splenectomy [13]. Although it was not beneficial in this instance, the authors suggested that rituximab should be considered prior to surgery when a woman is pregnant.
It is recommended to use these indices for the benefit of both the foetus and the mother, as anaemia and thrombocytopenia frequently coexist during pregnancy [14]. There is a direct correlation between Platelet Distribution Width (PDW) and severe thrombocytopenia, while an indirect correlation exists between PDW and mild thrombocytopenia [15]. Factors such as maternal fever and anaemia, foetal development issues, inappropriate alcohol consumption, blood-related procedures, and platelet transfusions are directly associated with thrombocytopenia during pregnancy.
The text discusses two postpartum ITP patients who received effective therapy in a tertiary hospital using Thrombopoietin Receptor Agonists (TPO-RA) [16]. The management of ITP during pregnancy relies on clinical expertise, and most of the TPO-RA usage in this context comes from case studies. If alternative treatments fail for severe ITP, the medication may be administered starting at 34 weeks. In certain pregnancies, the mother’s response to medication may vary, and in specific instances, it may be appropriate to induce labour.
The management of thrombocytopenia during pregnancy and outlines a decision-making process that considers factors such as the patient’s medical history, platelet count, and clinical examination to guide diagnostic and treatment strategies has been depicted in [Table/Fig-4].
Management of thrombocytopenia in pregnancy (Author).

Physicians, haematologists, and other healthcare professionals must adopt an integrated approach to address neutropenia during pregnancy to ensure the safety of both the mother and the unborn child [8]. Regular follow-up assessments and individualised treatment plans are crucial for achieving the best outcomes for pregnant individuals with thrombocytopenia. Similar cases are well-documented worldwide as well [9].
Conclusion(s)
The present case series highlights the importance of multidisciplinary management for complex obstetric patients with thrombocytopenia and multiple other co-morbidities. A collaborative effort among obstetricians, haematologists, physicians, and other specialists is essential to navigate the complexities of thrombocytopenia in pregnancy and to ensure optimal outcomes for both the mother and the baby, as evidenced by our patients.
[1]. Ruszala M, Poniedzialek-Czajkowska E, Mierzynski R, Wankowicz A, Zamojska A, Thrombocytopenia in pregnant womenGinekologia Polska 2021 92(8):587-90.10.5603/GP.a2021.014734541631 [Google Scholar] [CrossRef] [PubMed]
[2]. Efobi CC, Okoye HC, Korubo KI, Ezebialu IU, John OC, Evaluation of obstetricians’ opinion of thrombocytopenia in pregnancy: A cross-sectional studyWest Afr J Med 2022 39(7):657-62.35921687 [Google Scholar] [PubMed]
[3]. Zhou F, Xu T, Deng C, Yu H, Wang X, Severe thrombocytopenia in pregnancy: A case series from west ChinaClin Exp Med 2019 19(4):495-503.Epub 2019 Aug 2810.1007/s10238-019-00575-631463831 [Google Scholar] [CrossRef] [PubMed]
[4]. Committee on Practice Bulletins ObstetricsACOG practice bulletin no. 207: Thrombocytopenia in pregnancyObstet Gynecol 2019 133(3):e181-93.10.1097/AOG.0000000000003100 [Google Scholar] [CrossRef]
[5]. Eslick R, McLintock C, Managing ITP and thrombocytopenia in pregnancyPlatelets 2020 31(3):300-06.10.1080/09537104.2019.164087031296105 [Google Scholar] [CrossRef] [PubMed]
[6]. Subtil SFC, Mendes JMB, Areia ALFA, Moura JPAS, Update on thrombocytopenia in pregnancyRev Bras Ginecol Obstet 2020 42(12):834-40.Epub 2020 Dec 21. PMCID: PMC1030920110.1055/s-0040-172135033348401 [Google Scholar] [CrossRef] [PubMed]
[7]. Halici-Ozturk F, Ozturk M, Yakistiran B, Caglar AT, Engin-Ustun Y, Ozgu-Erdinc AS, Severe thrombocytopenia in pregnancy: A retrospective studyBlood Coagul Fibrinolysis 2020 31(8):517-21.10.1097/MBC.000000000000095532897892 [Google Scholar] [CrossRef] [PubMed]
[8]. Pishko AM, Levine LD, Cines DB, Thrombocytopenia in pregnancy: Diagnosis and approach to managementBlood Reviews 2020 40:100638Available from: https://doi.org/10.1016/j.blre.2019.10063810.1016/j.blre.2019.10063831757523 [Google Scholar] [CrossRef] [PubMed]
[9]. de Wet R, White S, Navadgi S, Chin J, Khor TS, Massive splenomegaly and thrombocytopenia in pregnancyPathology 2023 55(4):576-78.Epub 2022 Nov 2310.1016/j.pathol.2022.09.00636503637 [Google Scholar] [CrossRef] [PubMed]
[10]. Van Der Lugt NM, Kamphuis MM, Paridaans NP, Figee A, Oepkes D, Walther FJ, Neonatal outcome in alloimmune thrombocytopenia after maternal treatment with intravenous immunoglobulinBlood Transfus 2015 13(1):66-71.10.2450/2014.0309-13 [Google Scholar] [CrossRef]
[11]. Fogerty AE, Kuter DJ, How I treat thrombocytopenia in pregnancyBlood 2024 143(9):747-56.10.1182/blood.202302072637992219 [Google Scholar] [CrossRef] [PubMed]
[12]. Sousa MI, Braga AC, Buchner GC, Braga JS, Rituximab as a treatment for refractory immune thrombocytopenia during pregnancyBlood Coagul Fibrinolysis 2024 35(5):286-92.10.1097/MBC.000000000000131238973519 [Google Scholar] [CrossRef] [PubMed]
[13]. Priyanka B, Kavitha V, Priyadharshni P, Pavithra P, A prospective study of thrombocytopenia in pregnancy in a tertiary care centre, ChennaiInt J Acad Med Pharm 2024 6(4):60-63. [Google Scholar]
[14]. Marzooq AA, Husain AA, Naseeb AJ, Case of refractory thrombocytopenia in pregnancy associated with may-heglin anomaly after repeated platelet transfusionsOpen Journal of Obstetrics and Gynecology 2024 14(07):1083-90.10.4236/ojog.2024.147087 [Google Scholar] [CrossRef]
[15]. Mushahary D, Marwah S, Saran A, Gupta C, Kumari K, Malik S, Feto-maternal outcome in pregnancy with thrombocytopenia and abnormal platelet indicesCureus 2024 16(4):e5915610.7759/cureus.5915638803765 [Google Scholar] [CrossRef] [PubMed]
[16]. Sayed G, ElKourashy SA, Alnajjar M, Mallahi NA, Fareed S, Case report: Thrombopoietin receptor agonists in resistant thrombocytopenia in pregnancy: A case series and review of literatureFrontiers in Hematology 2023 2:118015610.3389/frhem.2023.1180156 [Google Scholar] [CrossRef]